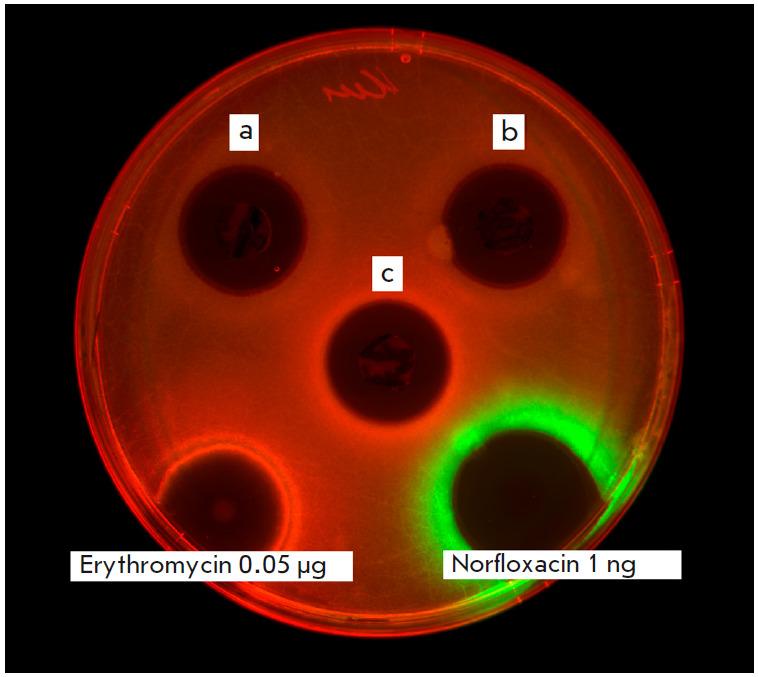
https://cdn.ncbi.nlm.nih.gov/pmc/blobs/e861/11062104/db3df6b36608/AN20758251-16-01-030-g003.jpg

产蒽醌链霉菌BV - 204、K - 1115A:一种新型蛋白质生物合成抑制剂
Streptomyces phaeochromogenes BV-204, K-1115A Anthraquinone-Producing Strain: A New Protein Biosynthesis Inhibitor.
作者信息
Belik A R, Zakalyukina Yu V, Alferova V A, Buyuklyan Y A, Osterman I A, Biryukov M V
机构信息
Sirius University of Science and Technology, Sochi, 354340 Russian Federation.
Lomonosov Moscow State University, Moscow, 119234 Russian Federation.
出版信息
Acta Naturae. 2024 Jan-Mar;16(1):30-39. doi: 10.32607/actanaturae.27315.
In the search for new antibiotics, it is a common occurrence that already known molecules are "rediscovered" while new promising ones remain unnoticed. A possible solution to this problem may be the so-called "target-oriented" search, using special reporter microorganisms that combine increased antibiotic sensitivity with the ability to identify a molecule's damaging effect. The use of such test organisms makes it possible to discover new promising properties even in known metabolites. In this study, we used a high-throughput screening method based on the pDualrep2 dual reporter system, which combines high sensitivity through the use of modified strains of test organisms and makes it possible to easily and accurately identify the interaction mechanisms of a substance and a bacterial cell at the initial stages of screening. This reporter system is unknown in Russia and is significantly superior to its global analogues. In the system, translation inhibition induces the expression of the fluorescent protein Katushka2s, while DNA damage is induced by TurboRFP. Using pDualrep2, we have isolated and described BV-204, an strain producing K-1115A, the biologically active substance that we have previously described. In our study, K-1115A for the first time has demonstrated antibiotic activity and an ability to inhibit bacterial translation, which was confirmed in a cell-free translation system for FLuc mRNA. K-1115A's antibacterial activity was tested and confirmed for (MRSA) and , its cytotoxicity measured against that for the HEK293 cell line. Its therapeutic index amounted to 2 and 8, respectively. The obtained results open up prospects for further study of K-1115A; so, this can be regarded as the basis for the production of semi-synthetic derivatives with improved therapeutic properties to be manufactured in dosage forms.
在寻找新型抗生素的过程中,经常会出现这样的情况:一些已知分子被“重新发现”,而新的有潜力的分子却未被注意到。解决这个问题的一个可能办法是所谓的“靶向”搜索,即使用特殊的报告微生物,这些微生物兼具对抗生素敏感性增强以及识别分子破坏作用的能力。使用这类测试生物体能够在已知代谢产物中发现新的有潜力特性。在本研究中,我们采用了基于pDualrep2双报告系统的高通量筛选方法,该系统通过使用经过改造的测试生物体菌株实现高灵敏度,并能在筛选初期轻松准确地识别物质与细菌细胞的相互作用机制。这种报告系统在俄罗斯并不为人所知,且明显优于全球同类产品。在该系统中,翻译抑制会诱导荧光蛋白Katushka2s的表达,而DNA损伤则由TurboRFP诱导。利用pDualrep2,我们分离并描述了BV - 204,这是一种产生K - 1115A的菌株,K - 1115A是我们之前描述过的生物活性物质。在我们的研究中,K - 1115A首次展现出抗生素活性以及抑制细菌翻译的能力,这在FLuc mRNA的无细胞翻译系统中得到了证实。对K - 1115A针对金黄色葡萄球菌(MRSA)和大肠杆菌的抗菌活性进行了测试并得到证实,还测定了其对HEK293细胞系的细胞毒性。其治疗指数分别为2和8。所获得的结果为进一步研究K - 1115A开辟了前景;因此,这可被视为生产具有改善治疗特性的半合成衍生物并制成剂型的基础。